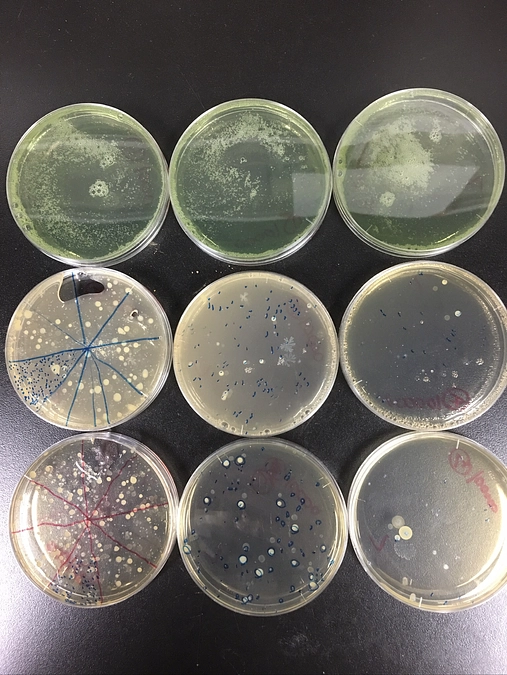
残り6日、最終目標達成まであと70万円強です！

支援総額
2,380,000円
目標金額 1,500,000円
- 支援者
- 139人
- 募集終了日
- 2025年3月31日
https://readyfor.jp/projects/onagawa?sns_share_token=&utm_source=pj_share_url&utm_medium=social
2025年03月26日 07:55
女川の森の現状
残り5日、最終目標達成まであと60万円強です!
この写真は、東北三霊場の一つで女川港から船で渡れる、金華山島の現状です。増えすぎたシカによる草木の侵食で地肌が剥き出しになり、植物も生えません。この荒廃した森は土砂崩れの危険が高く、森の生命を育む循環も生まれません
女川の森も同じく、人口減少は進み、森を管理する人もなく、シカは増える一方なので、金華山と同じ運命をたどるのは目に見えています
女川の森の木からワイン樽を作り、また樽財になる木を植樹し、間伐や整備を含めた森作りを行っていく。森に手を入れて、荒廃が進んでいる森林資源を活用し、管理することで、シカによる森林荒廃の被害や、その荒廃からくる土砂崩れを防ぎ、防災につなげていきたいと思っています
残り5日、最終目標達成まであと60万円強、頑張ります!
皆さま、最後まで応援よろしくお願い申し上げます!
ぜひ女川のワインと海の幸で乾杯しましょう🥂
リターン
3,000円+システム利用料

感謝のメール、ぶどう園便り
●感謝のメールをお送りします
●ぶどう園便りをお送りします(PDF形式でメールで月一回送付)
- 申込数
- 5
- 在庫数
- 制限なし
- 発送完了予定月
- 2025年3月
5,000円+システム利用料

感謝のメール、ぶどう園便り、オリジナルトートバッグ
●お礼のメールをお送りします
●ぶどう園便りをお送りします(PDF形式でメールで月一回送付)
●オリジナルトートバッグをお送りします
- 申込数
- 5
- 在庫数
- 制限なし
- 発送完了予定月
- 2030年3月
3,000円+システム利用料

感謝のメール、ぶどう園便り
●感謝のメールをお送りします
●ぶどう園便りをお送りします(PDF形式でメールで月一回送付)
- 申込数
- 5
- 在庫数
- 制限なし
- 発送完了予定月
- 2025年3月
5,000円+システム利用料

感謝のメール、ぶどう園便り、オリジナルトートバッグ
●お礼のメールをお送りします
●ぶどう園便りをお送りします(PDF形式でメールで月一回送付)
●オリジナルトートバッグをお送りします
- 申込数
- 5
- 在庫数
- 制限なし
- 発送完了予定月
- 2030年3月
1 ~ 1/ 15
このページを見た人はこんなプロジェクトもチェックしています
 コバルトーレ女川
コバルトーレ女川
 一般社団法人計算機と自然(代表:落合陽一)
一般社団法人計算機と自然(代表:落合陽一)
 公益社団法人Civic Force
公益社団法人Civic Force
 西成チャイルド・ケア・センター
西成チャイルド・ケア・センター
 国際文化交友会
国際文化交友会
 今川夏如(認定NPO法人みんなの夢の音楽隊)
今川夏如(認定NPO法人みんなの夢の音楽隊)
 吉村作治(エジプト考古学者)
吉村作治(エジプト考古学者)

女川から全国へ!コバルトーレ女川、JFL昇格チャレンジ
46%
- 現在
- 1,071,000円
- 支援者
- 75人
- 残り
- 17日

ぬるぬるのお引越|万博・落合陽一 null²パビリオン次なる場所へ
#ものづくり
216%
- 現在
- 216,849,000円
- 支援者
- 12,295人
- 残り
- 29日

【静岡県竜巻】緊急支援を開始!被災地を応援してください
56%
- 現在
- 568,000円
- 寄付者
- 69人
- 残り
- 20日

西成チャイルドサポーター募集|「おかえり」でつながる地域の実家を
継続寄付
- 総計
- 41人

プラネタリウム再生プロジェクト|星空を未来へつなぐ月光天文台の挑戦
21%
- 現在
- 2,155,000円
- 支援者
- 44人
- 残り
- 40日

アフガニスタン冬の食糧支援!飢餓が心配される子どもたちに給食を!
61%
- 現在
- 371,500円
- 寄付者
- 13人
- 残り
- 41日

吉村作治エジプト調査隊 太陽の船 大エジプト博物館展示へ【第一弾】
29%
- 現在
- 5,870,000円
- 支援者
- 153人
- 残り
- 67日